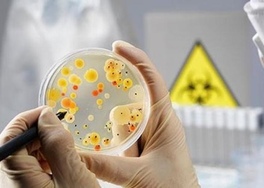
img

- Главная
- Ншанян Сона Юрьевна
Ншанян Сона Юрьевна

Задать вопрос
Клинические интересы
Владеет современными методами диагностики и лечения гинекологической и акушерской патологии, а также всеми методами вспомогательных репродуктивных технологий.
Образование
- Окончила с отличием Московскую Медицинскую Академию им. И.М. Сеченова по специальности лечебное дело.
- Клиническая ординатура на базе кафедры акушерства и гинекологии ММА им. И.М. Сеченова.
Последипломное образование
- Закончила аспирантуру на базе кафедры акушерства и гинекологии ММА им. И.М. Сеченова.
- 2003 — защитила кандидатскую диссертацию, посвященную диагностике и лечению структурно- функциональных нарушений эндометрия у женщин с бесплодием.
Повышение квалификации
- Специализации и сертификационные циклы на базе ведущих научных центров: Научного Центра Акушерства, Гинекологии и Перинатологии РАМН им. В.И. Кулакова, кафедры постдипломного образования ММУ им. И.М. Сеченова, кафедре постдипломного образования МГМСУ им. А.И. Евдокимова, ФГБУ "Научно-исследовательский институт акушерства и гинекологии им. Д.О. Отта, Российского университета дружбы народов ФПК МР.
- 2000 — сертификат специалиста по специальности «Акушерство и гинекология» ММА им. И.М. Сеченова.
- 2005 — сертификат специалиста по специальности «Акушерство и гинекология» МГМСУ.
- 2006 — свидетельство о повышении квалификации по «Вспомогательным репродуктивным технологиям» лечебно-профилактическом учебно-научном центре Санкт-Петербургского государственного университета.
- 2006 — сертификат специалиста по специальности «Акушерство и гинекология» Медицинского факультета СПГУ.
- 2010 — сертификат специалиста по специальности «Акушерство и гинекология» Российского Университета дружбы народов ФПК МР.
- 2015 — сертификат специалиста по специальности «Акушерство и гинекология» Академия медицинского образования.
- 2019 — сертификат специалиста по специальности «Ультразвуковая диагностика» «Российской медицинской академии непрерывного профессионального образования» МЗ РФ.
- 2020 — сертификат специалиста по специальности «Акушерство и гинекология» Академия медицинского образования.
- 2021 — удостоверение о повышении квалификации по « Современные возможности вспомогательных репродуктивных технологий» Академия медицинского образования.
- 2021 — удостоверение о повышении квалификации по «Актуальные вопросы ультразвуковой диагностики в акушерстве и гинекологии» Академия медицинского образования.
Достижения
- 2004 — диссертация «Диагностика и лечение структурно-функциональных нарушений эндометрия у женщин с бесплодием».
- Член Российской Ассоциации Репродукции Человека (РАРЧ).
- Член Европейского Общества Репродуктологов (ESHRE).
- Член Американское общество репродуктивной медицины (ASRM).
- Доцент кафедры акушерства, гинекологии и репродуктивной медицины ФПК МР РУДН.
- Автор и соавтор научных публикаций в сфере репродукции, в том числе и публикаций в ведущих отечественных и англоязычных изданиях.
- Общий стаж работы по специальности 25 лет, в репродуктивной медицине 20 лет.
- Активный участник многочисленных международных и регионарных форумов и конференций по репродуктивной медицине.
- Проводит обучающие семинары для врачей акушер-гинекологов.
- 2011-2022 — Постоянный участник конференций Российской ассоциации репродукции человека (РАРЧ).
- Участник конференций Европейское общество репродукции человека и эмбриологии (ESHRE) European Society of Human Reproduction and Embryology.
2013 — Лондон, Великобритания
2017 — Женева, Швейцария
2018 — Барселона, Испания
2019 — Вена, Австрия
2022 — Милан, Италия - 2017 — участник конференции OVARIAN CLUB, Барселона Испания.
- 2018 — участник INTERNATIONAL SUMMIT ON REPRODUCTION AND GENETICS IN ISRAEL (SARG), Тель Авив Израиль.
- 2016-2018 — участник и докладчик Status Praesens «Репродуктивный потенциал России».
- 2019 — участник конференции World Congress of the Academy of Human Reproduction, Дублин, Ирландия.
- Участник конференции European Society of Human Reproduction and Embryology (ESHRE).
К сожалению не только взрослые, но и дети болеют микоплазмозом. Так как многие женщины имеют в организме микоплазм, в частности беременные.
Микоплазмоз – половая инфекция, которая вызывается микроорганизмом под названием микоплазма. Существует очень много видов этого возбудителя. Патогенными для человека являются лишь несколько. Это такие виды как M.pneumoniae, M.fermentas, M.penetrans M.hominis, M.genitalium и Ureaplasma urealyticum.
Каждая женщина мечтает о здоровеньком малыше, чтобы ее беременность протекала гладко, с минимальным количеством посещений врача. Но, к сожалению это не всегда так, беременность – это вызов организму. Именно в этот период женщина наиболее уязвима. Могут проявляться дремлющие различные инфекции, обостряться многие хронические заболевания, так как при беременности происходит угнетение иммунитета.
В данной статье мы разберём такую важную тему, как микоплазмоз у женщин, причины, лечение. Микоплазмоз – это хроническая инфекция, которая развивается в урогенитальном тракте женщин и очень распространено современном мире.
Заболевания, передающиеся половым путем, в современном мире являются очень распространенными среди всех заболеваний женщин и мужчин репродуктивного возраста. К таким заболеваниям относится урогенитальный микоплазмоз и уреаплазмоз. К сожалению, достоверной информации насчёт некоторых видов микоплазм на данный момент нет. Многие исследователи и ученые расходятся во мнении причастности этих микроорганизмов к заболеваниям органов мочеполовой системы мужчин и женщин. Для определения значимости микоплазмы и уреаплазмы, которые вызывают урогенитальный микоплазмоз, дерматовенерология на данном этапе проводит множество исследований. И чтобы точно быть уверенными в истине, необходим еще не один год.